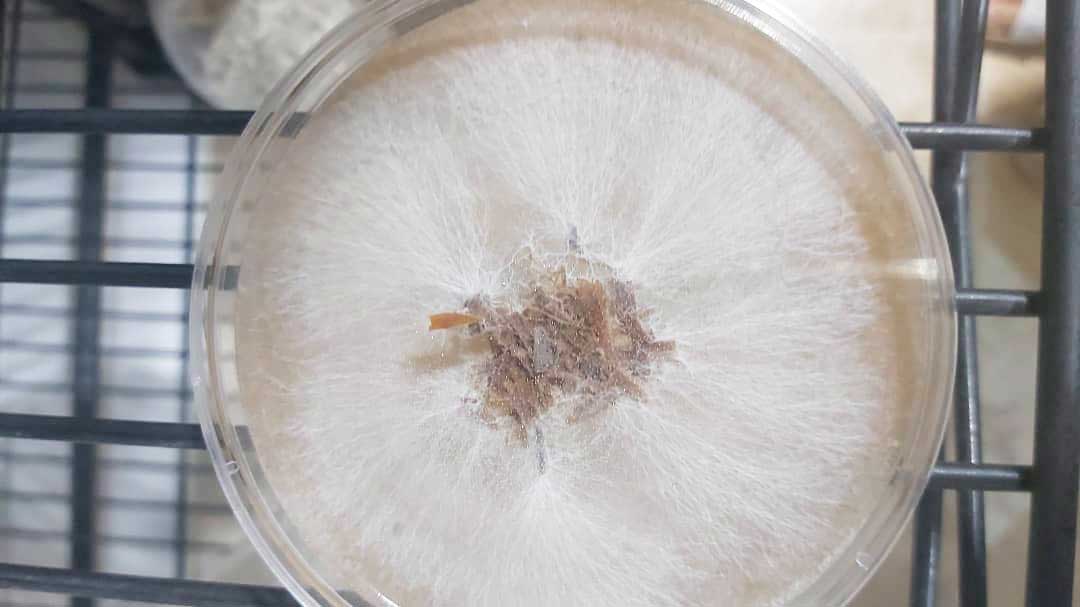
بذر قارچ

خلاصه از روش تولید بذر قارچ ، بذر قارچ دکمه ای
بذر قارچ های خوراکی در ایران بیش از 40 سال است که تولید می شود
اما متاسفانه پیشرفت چشمگیری نداشته و اگر چه در کشورهای پیشرفته بذر قارچ چندین سال است که تولید می شود اما در ایران بذر قارچ دو گونه خوراکی صدفی و قارچ دکمه ای بر روی دانه گندم پرورش می یابد.
نبود دستگاه های لازم از یک طرف و کمی دانش ژنتیک قارچ از طرف دیگر سبب شده تا بذر نسل 1 در ایران هنوز تولید نرسد ،آنچه در ایران عرضه می شود بذر قارچ نسل 2 است .
بذر قارچ های صدفی و بذر قارچ های دکمه ای تقریبا به صورت مشابه تولید و شرایط یکسان نگهداری می شود اما بذر قارچ هایی چون شی تا که و گنودرما بر روی خاک اره پرورش می یابد.
خوشبختانه طی سال های اخیر قارچهایی چون شی تا که( لنتینوس ادودز) ،گانودرما(گانودرما لوسیدم) و شاه صدف(پلوروتوس ارینجی) نیز در بازار خواهان دارند و بذر آنها نیز در برخی از واحدهای تولید کننده بذر قارچ ،تولید و عرضه می شوند.
بر خلاف قارچ دکمه ای پرورش قارچ در فضایی کوچکتر صورت می گیرد و روش تولید به این ترتیب است:
طیف وسیعی از دانه غلات می تواند بستر مسیلیوم قارچ جهت تولید بذر می باشد اما درایران این بستر دانه گندم دیم است در حالی که در اروپا بیشتر دانه چا و دار است که همین امر سبب افزایش کیفیت بذر قارچ در اروپا نسبت به ایران می شود.
روش تولید بذر قارچ خوراکی:
کیسه های پلی پروپیلن مقاوم به حرارت در سایزهای ۲۰ در ۵۰ و ۲۵ در ۵۰ ریخته می شود.درب کیسه ها ابتدا لوله گذاری و سپس پنبه گذاری می شود،سپس داخل دستگاهی به نام اتوکلاو قرار می گیرد. معمولا 2/3 فضای اتوکلاو از کیسه های بذر پر می شود.
گندم پس از خیساندن و پخته شدن برای تنظیم PH با مقداری کربنات کلسیم و سولفات کلسیم مخلوط می گردد و درون کیسه های پلی پروپیلین مقاوم به حرارت داخل دستگاهی به نام اتوکلاو می شود .
اتوکلاو در پزشکی ، داروسازی ، صنایع غذایی و … استفاده می شود .
این دستگا ها طی فشار و بخار عمل استریل کردن را انجام می دهد.
پس از خنک شدن گندم ، زیر دستگاهی بنام لامینار ایر فلو گندم با ریسه قارچ ( ریسه یا میسلیوم که بر روی پلیت حاوی محیط کشت PDA پرورش یافته است.)مخلوط می شود و به اتاق نگهداری منتقل می گردد.
این اتاق فاقد پنجره اما دارای ورودی هوای تازه است.
دمای نگهداری بذر 25 درجه سانتیگراد می باشد . هر چه این اتاق خشک تر باشد احتمال بروز الودگی ثانویه که معمولا از انواع کپک سبز است کمتر می شود .
بعد از 7 الی 10 روز کیسه های بذر آماده بر زدن یا اختلاط می شوند . پس از بر زدن 7 روز دیگر در همین شرایط نگهداری می شوند.
لازم به ذکر است که بذر قارچ صدفی نیازی به بر ثانویه ندارد اما بذر قارچ دکمه ای بهتر است یک بر ۷ روز بعد از تلقیح و بر دوم ۱۲ الی ۱۳ روز بعد از تلقیح بخورد که ریسه های بذر آگاریکوس به خوبی با تمام دانه های گندم مخلوط شوند.بذر قارچ دکمه ای معمولا روز ۱۶ الی ۱۷ آماده ارسال به واحد های کمپوست قارچ دکمه ای است.
بذر قارچ دکمه ای سالم کاملا سفید ، فاقد لکه های پودری رنگی است.
دانه دانه می باشد و با استشمام آن بوی قارچ به مشام می رسد در این شرایط می توان بذر را با کمپوست مخلوط کرد تا نهایتا میوه قارچ ظاهر شود .
اما اگر بذر قارچ تولیدی ما بذر قارچ صدفی باشد کاملا سفت و سفید است و اگر بر روی آن ضربه بزنید صدایی شبیه هندوانه رسیده و طبل تو خالی می دهد. بذر قارچ سالم باید فاقد بوی ترشیدگی و لکه های پودری به رنگهای مختلف (سبز، سیاه ، نارنجی) باشد.
انواع اسپان ها بذر قارچ به صورت تجاری
1) اسپان دانه غلات : 90% اسپان ها به صورت بذر قارچ دانه غلات است

2) اسپان مایع : کمتر از 5% اسپان ها به صورت مایع است
3 ) اسپان خاک اره : مخلوطی از ضایعات کشاورزی که غنی سازی شده است
نویسنده : ام هانی رمضانی

